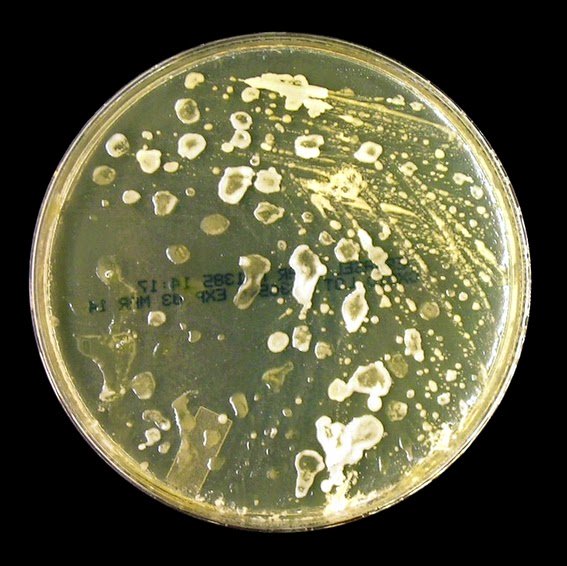

بالطبع التزريع للانسة فرفر على الاوساط الغذائية غير شائع (لعدم الحاجة) لسهولة الاستنتاج والتقصي واذا احتجنا لتزريعها لسبب او اخر نستخدم (SDA) مضاف له زيت طبيعي مثل زيت زيتون لأن الانسة تحب الجو الدهني (lipophilic) او ممكن نستخدم blood agar بس نضيف مصدر دهن طبيعي
Slow growing colonies, appearing at temperatures of 35-37ºC. Colonies begin shiny and white to cream later becoming dull and beige, resembling bacteria-like colonies. Growth takes around one to two weeks on modified SDA which must be supplemented with fatty acids
بحيث ان الكرات الصغيرة عبارة ( spores) والعصيات الطويلة تعتبر ( pseudohyphae)
فيه معلومة مهمة عن الانسة فرفر الانسة فرفر موجودة في اغلب البالغين البشر على الجلد وعلى فروة الرأس بشكل طبيعي ك ( normal flora) ولكن في حالات ممكن ان الجهاز المناعي يهاجمها خصوصاً لما تتكاثر بداخل بصيلات الشعر وتسبب لنا إلتهاب وأيضاً يوجد عوامل منها : الشعر والبشرة الدهنية...
أتمنى اني لخصت الموضوع بشكل جيد واحتاج ملاحظاتكم وأي زيادة ممكن انها تثري المحتوى ♥️?
#فضلها
#ريتويت
#شاركها
@kokofaris_ @DrSusanNasif @Lab_Diagnostics @SultanKahtani @haya_lab @LaboratoryInfo @Rawan_lab @labthology @ruqia_lab @SA_Microbiology @MicrobesInfect @LabTestKSA
#فضلها
#ريتويت
#شاركها
@kokofaris_ @DrSusanNasif @Lab_Diagnostics @SultanKahtani @haya_lab @LaboratoryInfo @Rawan_lab @labthology @ruqia_lab @SA_Microbiology @MicrobesInfect @LabTestKSA
Loading suggestions...